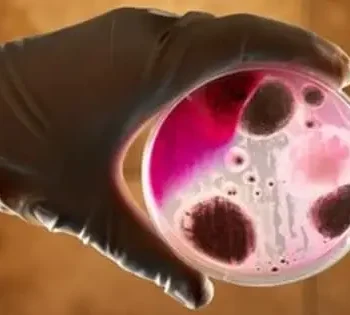

According to mouse cell research, correcting DNA disorganization in mouse cells may aid in the diagnosis and treatment of rare inherited diseases. Researchers say they
A team of researchers from the University of Minnesota Twin Cities' National Science Foundation Center for Sustainable Polymers has created a chemical method that combines fermentation and chemical refining to
People consume about the same amount whether it is hot or chilly outside. However, a fish's appetite varies greatly depending on the temperature. Their metabolism is influenced by environmental factors
The general structure of the antibody type IgE, which is the essential molecule in allergy disorders, has been described by an international research team. This is a significant scientific accomplishment
Scientists have shown that modifying an enzyme produced by the anthrax-causing bacterium can protect mice from infection with the deadly disease. Their findings, which were published today in the online